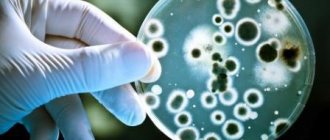

Very often people suffer from various gastrointestinal diseases. This may be due to poor environmental conditions, poor nutrition, lifestyle and other factors. Therefore, very often it is necessary to take an X-ray of the intestine in order to accurately diagnose a particular disease. And in this regard, many people have the question of intestinal x-rays, how are they done and how to prepare correctly for this procedure?
Indications for examination
As a rule, x-rays are prescribed to determine or confirm a diagnosis. An oncologist or therapist can give a referral for the procedure, but in most cases, radiography is recommended by a gastroenterologist.
Typically, this type of diagnosis is performed for the following ailments:
- difficulties in defecation are regularly observed for a long time;
- causeless stool disorder (constant diarrhea);
- chronic diseases of the gastrointestinal tract that are inflammatory in nature;
- blood or pus in the feces;
- determining the exact location of polyps, growths, malignant, benign formations or ulcers.
Also, an X-ray examination may be prescribed after surgery. This manipulation is necessary in order to check the patency of the organ, as well as the presence of possible adhesions.
Why is x-ray needed?
This manipulation is carried out to identify defects or pathologies in the organ. After assessing the condition, the doctor can draw conclusions about the presence of ailments.
Let's look at what this type of diagnostic shows:
- malignant or benign formation;
- diverticulitis;
- intestinal obstruction;
- the presence of polyps in the intestines.
Immediately after the examination, the radiologist prints out the images. The final diagnosis is made by the doctor (generalist or gastroenterologist) who referred the patient for this procedure.
Types of X-ray examination
This manipulation consists of shining through the human body or a certain area with x-rays that are invisible visually. X-ray examination is usually divided into two types:
- X-ray. Allows you to display a particular organ on a special screen in real time. Using the device, you can take several pictures and display them on the monitor.
- Radiography. This procedure involves photographing an organ or any part of the body using X-rays with the function of printing the images onto film. When performing radiography, it is possible to make a video recording.
It is worth noting that today a more modern study, radiography, is more often used.
The essence of barium diagnostics
Barium is a contrast agent that is necessary for examining the intestines. X-rays of the large and small intestine have some differences:
- A barium x-ray of the large intestine is performed by injecting a contrast agent into the rectum. This manipulation is also called irrigoscopy.
- X-rays of the small intestine are performed slightly differently. About 4-7 hours before, the patient needs to drink a pleasant-tasting drink that contains barium. The liquid is drunk in advance so that the active substance can enter the small intestine.
According to statistics, today X-rays with barium are performed much more often than without it. In approximately 87% of cases, a contrast agent is necessary for an accurate diagnosis.
Diagnosis of the small intestine
Before the X-ray examination, the patient needs to drink barium liquid. In the event that it is necessary to perform an X-ray examination of the stomach and intestines at the same time, the drink is taken orally with a special tube that supplies air.
If the contrast agent is unevenly distributed, the specialist applies light pressure on the abdominal cavity to distribute the liquid with barium suspension evenly.
A barium examination of the small intestine lasts on average 30 to 60 minutes. The doctor makes a conclusion based on how the contrast liquid fills the intestines: are there any gaps, perhaps the substance does not flow into some places at all, etc.
How is the colon examined?
How is irrigoscopy done? Barium is mixed with warm water and injected into the rectum using a device with a special tip. A total of about 3 liters of liquid is obtained. During insertion, the patient lies on the couch on his side, legs bent at the knees and close to the chest. To avoid possible complications, the contrast agent is injected very slowly.
X-rays are taken in different positions for the patient: the doctor asks to lie on the stomach, on the back, on the other side. After the X-ray examinations are completed, the doctor prescribes laxatives to quickly remove barium-containing fluid from the body.
After such a procedure, you must carefully monitor your well-being. Any changes in the functioning of the body may indicate any complications. In this case, you need to see a specialist.
Diseases that can be confirmed by irrigography
- Congenital intestinal pathology, Hirschsprung's disease, dolichosigma, dolichocolon.
- Crohn's disease.
- Ulcerative colitis.
- Intestinal dyskinesia (impaired motility).
- Intussusception. In addition, the examination from a diagnostic procedure can turn into a therapeutic one and straighten the “recession” of the intestinal wall directly during the examination due to air injection.
- Foreign bodies and injuries to the intestinal wall.
- Intestinal volvulus, which threatens intestinal obstruction.
After the study, the patient was recommended to follow a slag-free diet until stool normalization and use laxatives, because Barium sulfate provokes defecation disorders in the form of constipation.
How is the preparation carried out?
How to prepare for an intestinal x-ray? This question worries many who are about to undergo examination. Of course, before the x-ray, preparation for the procedure is necessary. Let's take a closer look:
- You need to abstain from junk food (fatty, spicy, smoked) at least three days before the intestinal examination. You should avoid any food that causes flatulence and bloating. Such products include brown bread, legumes, dairy products, fruits and some vegetables. Doctors advise giving preference to dairy-free cereal porridges and jelly, which, in turn, will help cleanse the intestines.
- Two days before the diagnosis, stop taking any medications. If you cannot do without the pill for health reasons, be sure to inform your doctor. As a rule, in such cases, the doctor recommends drinking a lot of fluids.
- Colon cleansing is carried out using liquid. You need to drink at least two liters per day. Experts do not prohibit drinking tea or juices, but the greatest benefit lies in drinking clean water.
- Literally a day before the scheduled examination, the doctor prescribes laxatives. The dosage and method of administration are discussed personally with the doctor.
- The doctor warns each patient that the maximum permitted body weight is no more than 150 kg.
- Typically, a session of this manipulation is scheduled for the morning so that the patient does not go without food for a long time. 20 hours before the examination, you must exclude solid foods from your diet. You can only consume liquids, these include: broths, water, tea. Never drink carbonated drinks or coffee.
- The final stage of preparation is a cleansing enema a couple of hours before the examination.
Many people are interested in how to cleanse the intestines before an x-ray of the lumbar region. It should be noted that before any examination (including an x-ray of the spine), the organ is cleaned in the same way as with an x-ray of the intestine.
Is the procedure harmful?
Many people believe that x-rays can harm the human body due to exposure to rays. In fact, this opinion is wrong. If certain precautions are taken, the procedure is completely safe.
Firstly, before starting the examination, the specialist takes into account the individual characteristics of the patient and contraindications to the procedure. Secondly, modern X-ray machines operate with a much lower proportion of radiation compared to older equipment. In any case, you definitely shouldn’t be afraid of exceeding the radioactive background (even if, for health reasons, you have to take several X-rays every year).
Some are afraid not of the procedure itself, but of the use of a contrast agent. The only possible consequence is an allergic reaction of the body, but this phenomenon is quite rare. Irrigoscopy causes problems with bowel movements in some people. This feature occurs very rarely, provided that the patient did not follow the doctor’s recommendations to take large amounts of water along with a laxative.
We can conclude that if you follow medical advice, x-rays are completely safe for the human body.
Contraindications
Like any other procedure, radiography or fluoroscopy has a number of contraindications. Let's consider the main ones:
- The period of bearing a child, especially if we are talking about an X-ray of the intestine with a contrast agent.
- Acute pain in the intestinal, spinal or lumbar region. Contraindications also include pain in any other organ, in which the patient cannot lie still.
- Intestinal biopsy, which was performed less than 1 month ago. This contraindication is due to the fact that when taking a biopsy, microdamages could remain on the intestinal mucosa. In this case, inflammation may occur when a contrast agent is injected.
- Intussusception (type of obstruction) of the intestine.
Contraindications
It is not recommended to examine the intestines using x-rays in the following cases:
- ulcerative colitis of destructive type;
- individual intolerance to barium;
- the presence of through wounds in the intestinal area;
- congenital enlargement of an internal organ;
- heart failure and rapid heart rate.
An absolute contraindication is pregnancy. If you are obese, it is also unacceptable to undergo the procedure, since the equipment is designed for 110-150 kg.
X-ray of the stomach with barium is contraindicated in the following cases: disturbances in the functioning of the hematopoietic system, a pathological condition associated with clouding of the lens of the eye, affecting visual acuity, oncopathology of the bronchopulmonary system, carrying a child at any stage, endocrine pathologies of the thyroid gland.
There are the following contraindications for performing an X-ray examination of the intestine:
- intestinal perforation;
- unconsciousness of the patient;
- general serious condition of the patient;
- nonspecific ulcerative colitis;
- a combination of segmental or total dilatation of the colon against the background of signs of systemic toxicity;
- severe diseases of the cardiovascular system;
- complete disruption of the passage of contents through the intestines;
- internal bleeding;
- severe pain in the epigastric region;
- pregnancy.
X-ray examination should not be performed after a recent intestinal biopsy, since the administration of contrast can provoke an inflammatory process at the sites where intestinal tissue is collected.
X-ray of the stomach is performed only in cases where it is impossible to perform gastroscopy or its data is insufficient to make a diagnosis
Patient reviews
The procedure is not very pleasant, but tolerable. In my case, the barium examination lasted about half an hour. There were no side effects after the procedure. The stool returned to normal within a day. The consequences were not a concern.
Ivan, 49 years old
I had an X-ray of my intestines with contrast many years ago, at that time medicine was not as advanced as it is today. But still, the specialist did his job perfectly; it was a little unpleasant when introducing liquid into the rectum, but tolerable. When I got home, I started taking laxatives, there were no problems.
Maria Petrovna, 60 years old
Due to health reasons, you have to do this examination from time to time. I believe that it is better to monitor your well-being and follow the doctor’s orders than to be afraid of diagnosis and let everything take its course.
Victoria, 42 years old
If, for health reasons, you need to undergo this type of diagnosis, you should under no circumstances refuse. From patient reviews, you can understand that the procedure is absolutely painless. Intestinal diseases are a serious pathology. If not treated promptly, health problems may arise. At the first signs of possible illnesses, be sure to contact a medical facility.
Bowel x-ray results
After the procedure, the study results are evaluated to determine pathologies. X-ray helps identify:
- the presence of acute intestinal obstruction – cup-shaped shadows in the image;
- impaired absorption - not a speckled pattern of the mucous membrane, deposition of barium on the walls in the form of flakes;
- polyps, diverticula – filling defects;
- malignant tumors – uneven filling of the lumen with contrast;
- megacolon – disruption of innervation, increase in the length of the colon.